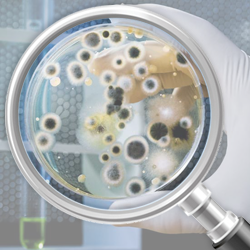

Главная
Мы оказываем услуги юридическим и физическим лицам на территории Санкт - Петербурга и Ленинградской области, возможен выезд экспертов в разные города РФ.
Мы работаем строго в соответствии с законодательством РФ: Гражданским процессуальным кодексом РФ и Федеральным законом от 31 мая 2001 г. N 73-ФЗ "О государственной судебно-экспертной деятельности в Российской Федерации", ст. 41.
Оценка проводится в соответствии с ФЗ от 29 июля 1998 г. N 135-ФЗ "Об оценочной деятельности в Российской Федерации" и Федеральными стандартами оценки (ФСО) (ознакомиться с полезной информацией можно в разделе «Информация»).
Все наши эксперты имеют высшее профильное образование, стаж работы по специальности от 10 лет, большой стаж экспертной деятельности, постоянно проходят курсы повышения квалификации и семинары.
Обратиться к нам за помощью можно:
по телефону 8 (921) 992 05 23
по электронной почте: expvspb.ru@mail.ru